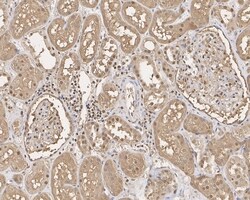
Invitrogen GAPDH Recombinant Rabbit Monoclonal Antibody (PD00-07) 100 &mu;L | Buy Online | Invitrogen&trade; | Fisher Scientific

Learn More
Invitrogen™ GAPDH Recombinant Rabbit Monoclonal Antibody (PD00-07)


Description
Positive control: HepG2 cell lysates, NIH/3T3 cell lysates, PC-12 cell lysates, THP-1 cell lysate, MCF-7 cell lysate, RH-35 cell lysate, L929 cell lysate, MEF cell lysate, HepG2 cell lysate, PC-12 cell lysate, L6 cell lysate, RAW264.7 cell lysate, A549 cell lysate, PMVEC cell lysate, NIH/3T3 cell lysate, human pancreas tissue. Predicted band size: 36 kDa Subcellular Location: Cytoskeleton, nucleus, cytosol, perinuclear region.

Specifications
Specifications
| Antigen | GAPDH |
| Applications | Flow Cytometry, Immunohistochemistry (Paraffin), Western Blot, Immunocytochemistry |
| Classification | Recombinant Monoclonal |
| Clone | PD00-07 |
| Concentration | 1 mg/mL |
| Conjugate | Unconjugated |
| Formulation | PBS with 0.1% BSA, 40% glycerol and 0.05% sodium azide; pH 7.4 |
| Gene | GAPDHS |
| Gene Accession No. | O14556, P04406, P04797, P16858, Q64467, Q9ESV6 |
| Gene Alias | 38 kDa BFA-dependent ADP-ribosylation substrate; aging-associated gene 9 protein; BARS-38; bb02e05; cb350; cb609; CDABP0047; EC 1.2.1.12; epididymis secretory protein Li 278; epididymis secretory sperm binding protein Li 162eP; fb71f08; fk58c09; G3PD; G3PDH; GAPD; GAPD2; gapdh; GAPDH2; GAPDH-2; GAPDHS; Gapds; Gapd-s; glceraldehyde-3-phosphate dehydrogenase; glyceraldehyde 3-phosphate dehydrogenase; glyceraldehyde 3-phosphate dehydrogenase, testis-specific; glyceraldehyde phosphate dehydrogenase; glyceraldehyde-3-phosphate dehydrogenase; glyceraldehyde-3-phosphate dehydrogenase (G3PDH); glyceraldehyde-3-phosphate dehydrogenase 2; glyceraldehyde-3-phosphate dehydrogenase GAPDH; glyceraldehyde-3-phosphate dehydrogenase like-17 protein; glyceraldehyde-3-phosphate dehydrogenase type 2; glyceraldehyde-3-phosphate dehydrogenase, spermatogenic; glyceraldehyde-3-phosphate dehydrogenase, testis-specific; glyceraldehyde-phosphate-dehydrogenase; glycerine aldehyde 3-phosphate dehydrogenase; HEL-S-162eP; HEL-S-278; HGNC:4141; HSD35; HSD-35; I79_001391; KNC-NDS6; LOW QUALITY PROTEIN: glyceraldehyde-3-phosphate dehydrogenase, testis-specific; mg:bb02e05; MGC128279 protein; MGC88685; multifunctional protein, glycolytic enzyme; OK/SW-cl.12; Peptidyl-cysteine S-nitrosylase GAPDH; similar to glyceraldehyde 3-phosphate dehydrogenase; spermatogenic cell-specific glyceraldehyde 3-phosphate dehydrogenase 2; Spermatogenic glyceraldehyde-3-phosphate dehydrogenase; Unknown (protein for IMAGE:8101613); unnamed protein product; wu:fb33a10; wu:fb71f08; wu:fk58c09; wu:ft80f05; zgc:76908 |
| Show More |
By clicking Submit, you acknowledge that you may be contacted by Fisher Scientific in regards to the feedback you have provided in this form. We will not share your information for any other purposes. All contact information provided shall also be maintained in accordance with our Privacy Policy.